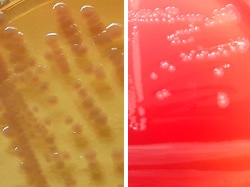

| C. kerstersii Gram staining |
| Comamonas kerstersii 48h colonies on MacConkey agar (left) and Sheep Blood Agar (right) |
| Comamonas kerstersii |
Positive results for catalase, nitrates reduction (but not nitrites), oxidase and tyrosine
hydrolysis.
Can utilize for growth: valerate, 3-hydroxybutyrate, L-proline, itaconate, suberate,
acetate, lactate and 4-hydroxybenzoate.
Simmons’ citrate agar test may be positive, but irregular and delayed.
Negative results for alkaline phosphatase, arginine dihydrolase, esculin hydrolysis,
gelatin hydrolysis, H2S production, indole production, lysine decarboxylase, ornithine
decarboxylase, pyrrolidone arylamidase and urease. Carbohydrates are neither
acidified nor assimilated.
Cannot utilize 3-hydroxybenzoate, L-alanine and glycine.
Variable results for the utilization of caprate.
hydrolysis.
Can utilize for growth: valerate, 3-hydroxybutyrate, L-proline, itaconate, suberate,
acetate, lactate and 4-hydroxybenzoate.
Simmons’ citrate agar test may be positive, but irregular and delayed.
Negative results for alkaline phosphatase, arginine dihydrolase, esculin hydrolysis,
gelatin hydrolysis, H2S production, indole production, lysine decarboxylase, ornithine
decarboxylase, pyrrolidone arylamidase and urease. Carbohydrates are neither
acidified nor assimilated.
Cannot utilize 3-hydroxybenzoate, L-alanine and glycine.
Variable results for the utilization of caprate.
Differential characters of C. testosteroni, C. terrigena, C. aquatica and C. kerstersii:
|
Taxonomy
Morphology
Cultural characteristics
Biochemical characters
Ecology
Pathogenicity
References
Phylum Pseudomonadota (Proteobacteria), Class Betaproteobacteria, Order Burkholderiales, Family Comamonadaceae, Genus
Comamonas, Comamonas kerstersii Wauters et al. 2003.
Syonyms: Comamonas kerstersii was previously known as Comamonas terrigena DNA group 3.
Comamonas, Comamonas kerstersii Wauters et al. 2003.
Syonyms: Comamonas kerstersii was previously known as Comamonas terrigena DNA group 3.
Gram-negative rods, Motile by multitrichous polar flagella, often with bipolar tufts.
After 24 h incubation at 30 ºC, colonies reach a diameter of 1.5 mm on blood agar
(more than 2 mm at 40 ºC). Grows aerobically on Tryptic Soy agar and broth at 30 and
35, 42 and 44 ºC; optimum at 35-40 ºC.
(more than 2 mm at 40 ºC). Grows aerobically on Tryptic Soy agar and broth at 30 and
35, 42 and 44 ºC; optimum at 35-40 ºC.
Isolated from human sample. Susceptible to desferrioxamine and colistin.
Undetermined.
- Wauters (G.), De Baere (T.), Willems (A.), Falsen (E.) and Vaneechoutte (M.):
Description of Comamonas aquatica comb. nov. and Comamonas kerstersii sp.
nov. for two subgroups of Comamonas terrigena and emended description of
Comamonas terrigena. Int. J. Syst. Evol. Microbiol., 2003, 53, 859-862. - Euzeby (J.P.): List of Bacterial Names with Standing in Nomenclature: a folder
available on the Internet. Int. J. Syst. Bacteriol., 1997, 47, 590-592. (List of
Prokaryotic names with Standing in Nomenclature. https://www.bacterio.net).

(c) Costin Stoica

| Antibiogram |
| Encyclopedia |
| Culture media |
| Biochemical tests |
| Stainings |
| Images |
| Movies |
| Articles |
| Identification |
| Software |
| R E G N U M PROKARYOTAE |

| Back |